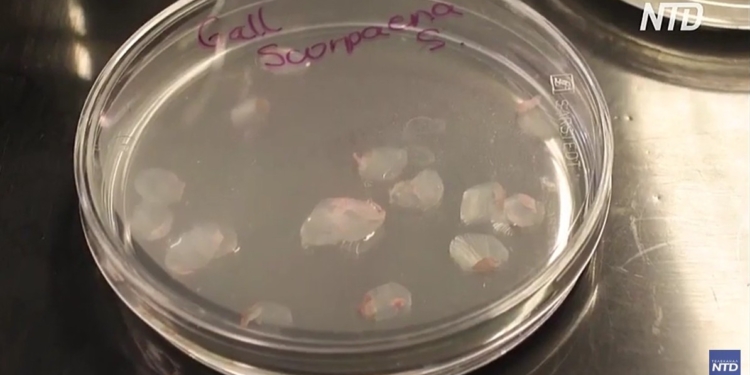
Вчені в Іспанії розробили штучну рогівку ока з риб’ячої луски (ВІДЕО)

Це відкриття може стати недорогою альтернативою донорській трансплантації.
Про це розповідається в сюжеті телеканалу NTD, передає Інше ТВ.
Науковці з Університету Гранади оголосили, що створили імплантати рогівки, які мають високу біосумісність, прозорість і міцність.
Риб’ячу луску беруть у поширених видів риб, наприклад, у коропів.
Рогівка – прозорий передній шар ока. Вона важко відновлюється при значному пошкодженні, оскільки в ній відсутні кровоносні судини та обмежена регенеративна здатність.
Важкі захворювання рогівки часто лікуються донорською трансплантацією. Однак існують обмеження, оскільки пацієнтам доводиться довго чекати на відповідний орган.
Співавтор дослідження Інгрід Гарсон каже, що луска може стати доступною і недорогою альтернативою. І водночас підтримати місцеву рибальську галузь.
Команда вже провела тестові операції на тваринах, і результати виявилися дуже обнадійливими.
Однак клінічні випробування на людях поки що не заплановані.
Як повідомляло Інше ТВ, Вчені дослідили чотири моделі харчування, пов’язані з довголіттям